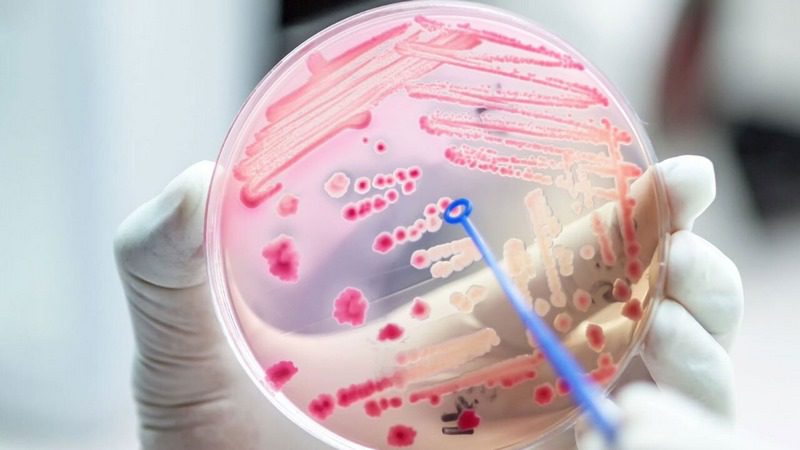
مقاومت ضدمیکروبی (AMR); هدف از پایش مقاومت ضد میکروبی و مبانی قانونی آن در اروپا

چرا پایش مقاومت ضد میکروبی (AMR) اهمیت دارد؟
مقاومت ضد میکروبی زمانی رخ میدهد که میکروبها (باکتریها، قارچها، انگلها) در برابر داروهای ضد میکروبی (آنتیبیوتیکها، آنتیفنجالها، ضد انگلها) مقاوم شوند و داروها دیگر به خوبی عمل نکنند. این پدیده خطر بزرگی برای سلامت انسان، حیوانات، تولید مواد غذایی و محیط زیست است
برای مثال، در منطقه اروپا/اقتصادی اروپا (EU/EEA) تخمین زده میشود که بیش از ۳۳٬۰۰۰ نفر سالانه مستقیماً به دلیل عفونتهای مقاوم به آنتیبیوتیک جان میدهند.
پایش (surveillance) در این زمینه یعنی «نظارت سیستماتیک و مرتب بر میزان مصرف آنتیبیوتیکها، شیوع میکروبهای مقاوم، روند تغییرات آنها و اثر اقدامات کنترلی». هدف پایش چندگانه است:
- شناسایی سریعتر روند ظهور مقاومت،
- امکان مقایسه بین کشورها یا بخشهای مختلف (بهداشت انسان، دام، محیط)،
- اطلاعرسانی تصمیمگیران برای سیاستگذاری،
- ارزیابی اثربخشی اقدامات و برنامهها
در واقع، بدون دادههای پایش، نمیتوان فهمید که آیا سیاستها مؤثر بودهاند یا خیر. مثلاً آیا مصرف آنتیبیوتیکها کاهش یافته؟ آیا شیوع میکروبهای مقاوم کم شده؟ بنابراین پایش، حلقهٔ حیاتی میان دانش (چه داریم؟) و عمل (چه باید بکنیم؟) است.
همچنین، از منظر اقتصادی و تولیدی، وقتی مقاومت زیاد شود، هزینههای درمانی افزایش مییابد، اثربخشی دارو پایین میآید، روندهای تولید در دام، آبزیپروری یا کشاورزی آسیب می بیند و امنیت غذایی تحت تاثیر قرار میگیرد.

اهداف مشخص پایش مقاومت در اروپا
در برنامهها و گزارشهای اتحادیه اروپا، اهداف مشخص برای پایش مقاومت ضد میکروبی بیان شده است. به چند مورد اشاره میکنم:
- اطمینان از استفاده معقول و بهینه از داروهای ضد میکروبی در انسان و حیوان
- ارتقاء سیستمهای پایش و نظارت در حوزه بهداشت انسان، دام، محیط؛
- کاهش شیوع عفونتهای مقاوم به دارو و بهبود اطلاعرسانی، آموزش و فرهنگسازی در میان عامه مردم، پزشکان، دامپزشکان.
- تشویق تحقیق، نوآوری و دسترسی به داروها، واکسنها یا روشهای جایگزین.
با داشتن این اهداف، پایش نه فقط «اندازهگیری مقاومت» بلکه «مسیری برای کنترل» میشود. یعنی دادههای پایش باید با سیاستها و مداخلات مرتبط باشند.

مبانی قانونی و راهبردی در اتحادیه اروپا
سندهای راهبردی
- در سال ۲۰۱۱، کمیسیون اروپا سند «کارزار علیه تهدیدهای فزاینده مقاومت ضد میکروبی» را منتشر کرد که اهداف کلی از جمله پایش را تعیین کرد.
- سپس در سال ۲۰۱۷، طرح راهبردی European One Health Action Plan Against AMR با رویکرد «یک سلامت» (One Health: انسان، حیوان، محیط تصویب شد.
- اخیراً نیز، در سال ۲۰۲۳، توصیهنامهای از سوی شورای اروپا برای تقویت اقدامات اتحادیه در حوزه AMR با تأکید بر پایش و نظارت منتشر شد.
مقررات و قوانین خاص
- Regulation (EU) 2019/6 در مورد محصولات دارویی دامپزشکی؛
- Regulation (EU) 2019/4 در مورد خوراک دارویی (medicated feed)؛
- اخیراً نیز، مقرراتی برای تقویت نظارت بر محیط، آب و خاک (مانند Directive 2000/60/EC چارچوب سیاست آب، مقررات کیفی آب) که با بحث ذرات دارویی و مقاومت میکروبی در محیط در ارتباط اند.
دلیل ضرورت قانونی
از منظر قانونی، اتحادیه اروپا میبیند که مقاومت ضد میکروبی نه فقط یک موضوع بهداشت انسانی است، بلکه مسئلهای بین بخشی است که دام، کشاورزی و محیط را دخیل میکند. لذا قانونگذاریها باید بر پایهٔ دادهها و نظارت دقیق باشند (که پایش را الزامی میکند). به عنوان مثال، گزارشها نشان میدهند که آنتیبیوتیکها در حیوانات تولید غذا همچنان مصرف بالایی دارند و مقاومت در این بخش قابل توجه است.

چرا پایش مقاومت در محیط و آب نیز اهمیت دارد؟
اکثر تمرکز شاید روی انسان و دام بوده، اما محیط (آبهای سطحی، فاضلاب، خاک) نیز نقش اساسی دارد: داروها، متابولیتها، میکروبهای مقاوم از طریق خروجیها به محیط وارد میشوند و میتوانند ژنهای مقاومت را پخش کنند. این امر خطر گسترش مقاومت را افزایش میدهد.
از اینرو، قانونگذاری محیطی و شاخصهای پایش آب، خاک و فاضلاب نیز در چارچوب راهبرد AMR مطرح شدهاند.
چالشها و فرصتها در پایش مقاومت آنتی بیوتیکی
پایش مقاومت در اروپا با پیشرفتهای زیادی همراه بوده، اما هنوز چالشهایی وجود دارد:
- نبود دادههای یکنواخت، مقایسهپذیر بین کشورها یا بخشها.
- تمرکز بیشتر روی بهداشت انسان نسبت به دام یا محیط؛ بخش محیطی اغلب کمتر دیده شده است.
- نیاز به روشهای تشخیصی سریع، استانداردسازی آزمایشها، و تبادل دادهها.
- پایش مصرف آنتیبیوتیکها، روند شیوع مقاومت، و تأثیر مداخلات، نیاز به منابع مالی، فنی و سازمانی دارد.

از سوی دیگر، فرصتها نیز فراواناند:
- با تقویت پایش، امکان «هدفگذاری» (مثلاً کاهش مصرف دارو، کاهش شیوع مقاومت) وجود دارد.
- دادههای پایش میتوانند مبنای سیاستگذاری بهینهتر، آموزش بهتر و نوآوری دارویی شوند.
- همکاری بین بخشی (انسان، دام، محیط) با استفاده از رویکرد One Health میتواند اثربخشی را افزایش دهد.
نتیجهگیری
پایش مقاومت ضد میکروبی در اتحادیه اروپا یکی از ستونهای کلیدی در مبارزه با این تهدید بزرگ سلامت است. بدون داشتن دادههای دقیق، روندها قابل ردیابی نیستند و سیاستها نمیتوانند به درستی ارزیابی شوند. مبانی قانونی و راهبردی اتحادیه اروپا، با تأکید بر رویکرد One Health، چارچوبی فراهم کردهاند که استفاده معقولتر از داروها، کاهش مصرف و گسترش نظارت را تشویق میکند. اما هنوز راه درازی پیش است تا دادهها و سیستمهای پایش به سطحی برسند که بتوانند پاسخگوی چالشهای آینده باشند.